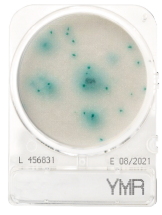
CompactDry YMR (rapid) - Yeast and mould

Compactdry | SKU:
2192031
CompactDry YMR (rapid) - Yeast and mould
Reguliere prijs
€67,95
Eenheid prijs
Waarom bestellen bij Antonides?
✅Persoonlijk en betrouwbaar
✅Flexibel en op maat
Snelle detectie van gisten en schimmels met CompactDry YMR. Verkort incubatietijden voor een efficiëntere kwaliteitscontrole.
-
Merk
-
Merk artikelnummer
Afbeeldingen dienen ter illustratie. Product kan afwijken van de getoonde foto.